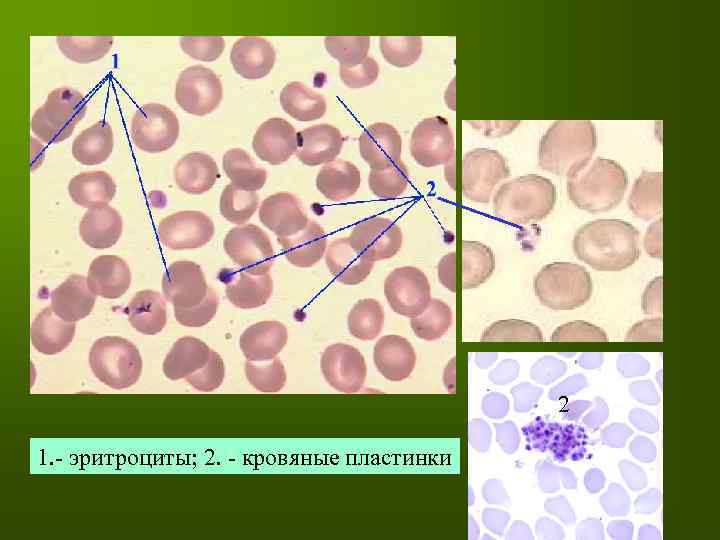
2 1. - эритроциты; 2. - кровяные пластинки

Кровь.ppt
- Количество слайдов: 54

ТКАНИ ВНУТРЕННЕЙ СРЕДЫ КРОВЬ

Общие признаки соединительных тканей (тканей внутренней среды) 1. 2. 3. 4. 5. Развитие в эмбриогенезе из общего источника – мезенхимы; Высокое содержание межклеточного вещества; Рыхлое расположение клеточных элементов; Гетерогенность и гетероморфность клеточных элементов; Отсутствие полярности клеток;

МЕЗЕНХИМА

МЕЗЕНХИМА

Ткани внутренней среды Кровь, лимфа Скелетные ткани Соединительные ткани Кости Хрящи Волокнистые ткани Рыхлая соединительная Со спец. свойствами Ретикулярная Плотная соединительная Неоформленная Оформленная Студенистая Жировая

Мазок крови человека

1. 2. 3. 4. 5. 6. Функции крови: Обеспечение гомеостаза Дыхательная Трофическая Экскреторная Регуляторная Защитная

ЭРИТРОЦИТЫ постклеточные структуры. Д- 7. 2 – 7. 5 мкм; 4. 5 -5. 5 млн/мкл Функции эритроцитов: дыхательная, регуляторная, защитная

Варианты строения эритроцитов

Цитоскелет эритроцита

Серповидные эритроциты

Эритроциты в капиллярах

Ретикулоциты

Эритроциты в кровеносном сосуде

ЛЕЙКОЦИТЫ По строению и функциям разнообразны, подвижны. Циркулируют в крови, участвуют в защитных реакциях после выхода в соединительную ткань.

Перемещения лейкоцитов в сосудах и вне их

Проникновение лейкоцитов через стенку кровеносных сосудов

НЕЙТРОФИЛЫ (нейтрофильные гранулоциты). Д 10 -15 мкм Самые многочисленные гранулоциты - 65 -75% Находятся в крови 8 -12 часов, в тканях 5 -7 суток. Их основная функция – антибактериальная защита и участие в воспалительных реакциях

Варианты строения ядер сегментоядерных нейтрофилов на мазке

Ультраструктура нейтрофила

ЦИТОПЛАЗМАТИЧЕСКИЕ ГРАНУЛЫ НЕЙТРОФИЛОВ Первичные (неспецифические, азурофильные) секреторные гранулы: Д- 500 нм, содержат лизоцим, миелопероксидазу, протеиназы (нейтр. ), гидролазы (кисл. ), катионные белки, бактерицидный белок и др. Вторичные – специфические – гранулы: Д – 200 нм, содержат лизоцим, лактоферрин, щелочную фосфатазу, коллагеназу, активатор плазминогена, адгезивные белки. Третичные (желатиназные) гранулы: содержат желатиназу, адгезивные белки, лизоцим и др. ферменты. Секреторные пузырьки, в их мембранах имеются адгезивные белки и рецепторы

Ультраструктура нейтрофила

БАЗОФИЛЫ Встречаются очень редко - 0. 5 – 1. 0%. Д -10 -12 мкм. Циркулируют в крови 6 -24 часа, в соединительной ткани находятся от нескольких часов до нескольких суток. Основные функции – регуляция процессов свертывания крови и проницаемости сосудов, участие в иммунных реакциях

БАЗОФИЛЫ

Ультраструктура базофила

Цитоплазматические гранулы базофилов Специфические гранулы крупные (Д - 1. 5 мкм), содержат гепарин, хондроитин сульфат, гистамин, протеазы, пероксидазу, АТФ, простагландины, хемотаксические факторы эозинофилов и нейтрофилов Неспецифические азурофильные гранулы содержат ферменты лизосом

Варианты выделения содержимого секреторных гранул из базофила

Участие базофилов в аллергических реакциях

ЭОЗИНОФИЛЫ 2 – 5% (Д 12 -17 мкм), находятся в крови 7 - 12 часов, в соединительной ткани 8 -12 суток. Основные функции – а) антипротозойная и антибактериальная защита; б) иммунорегуляторная – ограничение областей иммунных реакций; выработка цитокинов и медиаторов воспаления.

ЭОЗИНОФИЛЫ

Ультраструктура эозинофила

Цитоплазматические гранулы эозинофилов Специфические гранулы величиной 0. 5 – 1. 5 на 0. 3 мкм содержат кристаллоид, в котором находится главный основной белок с большим количеством аргинина, миелопероксидазу, гидролитические ферменты В матриксе гранул: эозинофильный катионный белок, эозинофильная пероксидаза, эозинофильный нейротоксин, гистаминаза Второй тип гранул Д - 0. 1 – 0. 5 мкм (азурофильные неспецифические) гомогенные, содержат арилсульфатазу, гистаминазу, кислую фосфатазу

МОНОЦИТЫ 6 – 8 % самые крупные лейкоциты (Д - до 20 мкм), В крови от 8 часов до 3 -4 суток, в тканях содержатся в 20 раз больше, чем в крови, превращаются в макрофаги и образуют систему мононуклеарных фагоцитов. Основные функции – фагоцитоз, представление антигенов; - регуляция состояния межклеточного вещества, функциональной активности и пролиферации клеток различных типов.



Ультраструктура моноцита

Ультраструктура моноцита

В цитоплазме моноцитов имеются только азурофильные гранулы. Специфические гранулы отсутствуют. Антимикробные системы моноцитов включают лизоцим, лактоферрин, арилсульфатазу, кислую фосфатазу, катионные белки, миелопероксидазу, перекись водорода, окись азота и др.

Моноцит крови Варианты дифференцировки моноцитов в тканях

ЛИМФОЦИТЫ 25 – 30% По величине различают малые (Д - 4. 5 -6 мкм), средние (Д – 7 – 10 мкм) и большие (Д - больше 10 мкм). Их главная функция - а) обеспечение иммунных реакций; б) регуляция деятельности клеток других типов.

мелкий средний ЛИМФОЦИТЫ большой

лимфоцит

ЛИМФОЦИТ

Содержание в крови различных видов лимфоцитов Т- лимфоциты - 70 -80% В – лимфоциты 10 – 20 % О – лимфоциты 5 -10 %

Пути циркуляции лимфоцитов Путь быстрой циркуляции: Кровь - посткапиллярные венулы периферических органов иммунной системы – Т - и В - зависимые зоны лимф. сосуды – грудной лимф. проток – кровь. Путь медленной циркуляции: Кровь - посткапиллярные венулы неиммунных органов – периферические ткани – афферентные лимф. сосуды – лимфатические узлы – лимф. сосуды - грудной лимф. проток – кровь. В селезенку и из нее лимфоциты направляются по кровеносным сосудам.

КРОВЯНЫЕ ПЛАСТИНКИ (Д 2 – 4 мкм) Концентрация в крови – 200 – 400 тыс/мкл Циркулируют в крови 5 -10 дней, разрушаются в селезенке Функции кровяных пластинок (тромбоцитов): 1. Остановка кровотечения при повреждении стенки сосуда 2. Обеспечение гемокоагуляции 3. Участие в реакциях заживления ран 4. Обеспечение нормального функционирования эндотелия
2 1. - эритроциты; 2. - кровяные пластинки

Кровяные пластинки (вид сверху и сбоку)

СОДЕРЖИМОЕ ГРАНУЛ КРОВЯНЫХ ПЛАСТИНОК α – гранулы (Д 300 - 500 нм) умеренно плотные содержат фибриноген, фибронектин, тромбоспондин, тромбоглобулин, ТФР, фактор свертывания V, фактор Виллебранда и др. δ - гранулы (Д 250 – 300 нм) плотные, содержат АДФ, АТФ, Са, Мg, пирофосфат, гистамин, серотонин λ - гранулы (Д 200 – 250 нм) содержат гидролитические ферменты

Реакция кровяных пластинок на повреждение стенки сосуда


3. Третичные желатиназа, лизоцим, адгезивные белки НЕЙТРОФИЛ

Эозинофил

МОНОЦИТ
Кровь.ppt